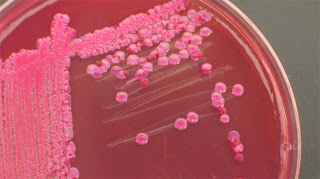

Το παθογόνο στέλεχος του βακτηρίου Escherichia coli, που ευθύνεται για την επιδημία αιμορραγικής γαστρεντερίτιδας στη Γερμανία, ζει κανονικά στο πεπτικό σύστημα των βοοειδών και άλλων μηρυκαστικών ζώων, χωρίς να τους προκαλεί συμπτώματα.
Στον άνθρωπο, το συγκεκριμένο στέλεχος...
με την ονομασία Escherichia coli O157:H7, προκαλεί πόνους στην κοιλιά και σοβαρή διάρροια, συνήθως συνοδευόμενη από αιμορραγία. Οι ασθενείς συχνά παραμένουν απύρετοι και στις περισσότερες περιπτώσεις αναρρώνουν πλήρως έπειτα από πέντε με οκτώ ημέρες.
Στο 2 με 7 τοις εκατό των κρουσμάτων, κυρίως σε νήπια κάτω των πέντε ετών, η λοίμωξη με εντεροαιμορραγική E.coli (EHEC) μπορεί να οδηγήσει σε «αιμολυτικό ουραιμικό σύνδρομο» (HUS), μια επείγουσα κατάσταση που χαρακτηρίζεται από καταστροφή των ερυθρών αιμοσφαιρίων και νεφρική ανεπάρκεια.
Από τους ασθενείς που εμφανίζουν το σύνδρομο, το 93 με 95 τοις εκατό καταφέρνει να αναρρώσει έπειτα από μεταγγίσεις και αιμοκάθαρση στη μονάδα εντατικής θεραπείας.
Τα αντιβιοτικά έχουν περιορισμένη αποτελεσματικότητα σε αυτή τη λοίμωξη και συχνά αντενδείκνυνται λόγω του κινδύνου περαιτέρω νεφρικής βλάβης.
Αποτελεσματικό κατά του συνδρόμου φαίνεται ότι είναι πάντως το μονοκλωνικό αντίσωμα εκουλιζουμάμπη, το οποίο αναπτύχθηκε για μια εντελώς διαφορετική ασθένεια του αίματος, αλλά δοκιμάζεται τώρα και σε θύματα της επιδημίας στη Γερμανία.
Η παθογένεια του E. coli O157:H οφείλεται κυρίως στις τοξίνες που παράγει (τοξίνες Σίγκα), παρόμοιες με την τοξίνη ρισίνη του ρετσινόλαδου, η οποία έχει χρησιμοποιηθεί ως βιολογικό όπλο. Σε αντίθεση με τον άνθρωπο, τα βοοειδή δεν διαθέτουν υποδοχείς για αυτές τις τοξίνες, γι΄αυτό και έχουν ανοσία.
Οδοί μετάδοσης
Το E. coli O157:H αναγνωρίστηκε για πρώτη φορά το 1983, όταν προκάλεσε επιδημία γαστρεντερίτιδας στις ΗΠΑ λόγω της κατανάλωσης μισοψημένων χάμπουργκερ.
Η κατανάλωση μολυσμένου μοσχαρίσιου κιμά είναι η κύρια αιτία λοίμωξης, ωστόσο το βακτήριο μεταδίδεται επίσης από μη παστεριωμένο γάλα και χυμούς, λαχανικά και αλλαντικά.
Οι κυριότεροι τρόποι πρόληψης είναι το τακτικό πλύσιμο των χεριών, το μαγείρεμα των τροφίμων και το καλό πλύσιμο των λαχανικών που καταναλώνονται ωμά.
Το μαγείρεμα καταστρέφει όχι μόνο το βακτήριο, αλλά και την τοξίνη που παράγει.
Η Escherichia coli (προφέρεται «εσερίχια κόλι») είναι κολοβακτηρίδιο, ζει δηλαδή κανονικά στο πεπτικό σύστημα διαφόρων ζώων. Απαντάται σε πολλά διαφορετικά στελέχη, από τα οποία τα περισσότερα είναι ακίνδυνα και αποτελούν μέρος της μικροχλωρίδας του ανθρώπινου εντέρου.
Όπως όλα τα στελέχη του βακτηρίου, το επικίνδυνο στέλεχος O157:H7 μεταδίδεται συνήθως μέσω της λεγόμενης πρωκτοφαρυγγικής οδού: σωματίδια από μολυσμένα κόπρανα τα οποία φτάνουν τελικά στο στόμα του νέου ξενιστή.
Αυτό μπορεί να συμβεί:
Από την κατανάλωση μη αποστειρωμένου νερού ή τροφίμων, τα οποία έχουν μολυνθεί από κόπρανα ζώων, για παράδειγμα κατά τη σφαγή.
Από το κολύμπι σε μολυσμένα νερά
Από μύγες που έχουν έρθει σε επαφή με κόπρανα ή μη επεξεργασμένα λύματα.
Από την επαφή με μολυσμένα ζώα
Από άνθρωπο σε άνθρωπο όταν δεν τηρούνται οι κανόνες καθαριότητας στην τουαλέτα
Από σεξουαλικές πρακτικές στις οποίες μπορεί να υπάρξει επαφή με σωματίδια κοπράνων
Δυστυχώς, το O157:H7 είναι εξαιρετικά μολυσματικό σε σχέση με άλλα στελέχη E.coli. Ακόμα και 10 έως 100 κύτταρα του βακτηρίου αρκούν για να εμφανιστεί λοίμωξη.
Η περίοδος επώασης, δηλαδή ο χρόνος που μεσολαβεί από τη μόλυνση μέχρι την εμφάνιση των συμπτωμάτων, μπορεί να φτάσει τις οκτώ ημέρες.
Πηγή: tanea
Στον άνθρωπο, το συγκεκριμένο στέλεχος...
με την ονομασία Escherichia coli O157:H7, προκαλεί πόνους στην κοιλιά και σοβαρή διάρροια, συνήθως συνοδευόμενη από αιμορραγία. Οι ασθενείς συχνά παραμένουν απύρετοι και στις περισσότερες περιπτώσεις αναρρώνουν πλήρως έπειτα από πέντε με οκτώ ημέρες.
Στο 2 με 7 τοις εκατό των κρουσμάτων, κυρίως σε νήπια κάτω των πέντε ετών, η λοίμωξη με εντεροαιμορραγική E.coli (EHEC) μπορεί να οδηγήσει σε «αιμολυτικό ουραιμικό σύνδρομο» (HUS), μια επείγουσα κατάσταση που χαρακτηρίζεται από καταστροφή των ερυθρών αιμοσφαιρίων και νεφρική ανεπάρκεια.
Από τους ασθενείς που εμφανίζουν το σύνδρομο, το 93 με 95 τοις εκατό καταφέρνει να αναρρώσει έπειτα από μεταγγίσεις και αιμοκάθαρση στη μονάδα εντατικής θεραπείας.
Τα αντιβιοτικά έχουν περιορισμένη αποτελεσματικότητα σε αυτή τη λοίμωξη και συχνά αντενδείκνυνται λόγω του κινδύνου περαιτέρω νεφρικής βλάβης.
Αποτελεσματικό κατά του συνδρόμου φαίνεται ότι είναι πάντως το μονοκλωνικό αντίσωμα εκουλιζουμάμπη, το οποίο αναπτύχθηκε για μια εντελώς διαφορετική ασθένεια του αίματος, αλλά δοκιμάζεται τώρα και σε θύματα της επιδημίας στη Γερμανία.
Η παθογένεια του E. coli O157:H οφείλεται κυρίως στις τοξίνες που παράγει (τοξίνες Σίγκα), παρόμοιες με την τοξίνη ρισίνη του ρετσινόλαδου, η οποία έχει χρησιμοποιηθεί ως βιολογικό όπλο. Σε αντίθεση με τον άνθρωπο, τα βοοειδή δεν διαθέτουν υποδοχείς για αυτές τις τοξίνες, γι΄αυτό και έχουν ανοσία.
Οδοί μετάδοσης
Το E. coli O157:H αναγνωρίστηκε για πρώτη φορά το 1983, όταν προκάλεσε επιδημία γαστρεντερίτιδας στις ΗΠΑ λόγω της κατανάλωσης μισοψημένων χάμπουργκερ.
Η κατανάλωση μολυσμένου μοσχαρίσιου κιμά είναι η κύρια αιτία λοίμωξης, ωστόσο το βακτήριο μεταδίδεται επίσης από μη παστεριωμένο γάλα και χυμούς, λαχανικά και αλλαντικά.
Οι κυριότεροι τρόποι πρόληψης είναι το τακτικό πλύσιμο των χεριών, το μαγείρεμα των τροφίμων και το καλό πλύσιμο των λαχανικών που καταναλώνονται ωμά.
Το μαγείρεμα καταστρέφει όχι μόνο το βακτήριο, αλλά και την τοξίνη που παράγει.
Η Escherichia coli (προφέρεται «εσερίχια κόλι») είναι κολοβακτηρίδιο, ζει δηλαδή κανονικά στο πεπτικό σύστημα διαφόρων ζώων. Απαντάται σε πολλά διαφορετικά στελέχη, από τα οποία τα περισσότερα είναι ακίνδυνα και αποτελούν μέρος της μικροχλωρίδας του ανθρώπινου εντέρου.
Όπως όλα τα στελέχη του βακτηρίου, το επικίνδυνο στέλεχος O157:H7 μεταδίδεται συνήθως μέσω της λεγόμενης πρωκτοφαρυγγικής οδού: σωματίδια από μολυσμένα κόπρανα τα οποία φτάνουν τελικά στο στόμα του νέου ξενιστή.
Αυτό μπορεί να συμβεί:
Από την κατανάλωση μη αποστειρωμένου νερού ή τροφίμων, τα οποία έχουν μολυνθεί από κόπρανα ζώων, για παράδειγμα κατά τη σφαγή.
Από το κολύμπι σε μολυσμένα νερά
Από μύγες που έχουν έρθει σε επαφή με κόπρανα ή μη επεξεργασμένα λύματα.
Από την επαφή με μολυσμένα ζώα
Από άνθρωπο σε άνθρωπο όταν δεν τηρούνται οι κανόνες καθαριότητας στην τουαλέτα
Από σεξουαλικές πρακτικές στις οποίες μπορεί να υπάρξει επαφή με σωματίδια κοπράνων
Δυστυχώς, το O157:H7 είναι εξαιρετικά μολυσματικό σε σχέση με άλλα στελέχη E.coli. Ακόμα και 10 έως 100 κύτταρα του βακτηρίου αρκούν για να εμφανιστεί λοίμωξη.
Η περίοδος επώασης, δηλαδή ο χρόνος που μεσολαβεί από τη μόλυνση μέχρι την εμφάνιση των συμπτωμάτων, μπορεί να φτάσει τις οκτώ ημέρες.
Πηγή: tanea
Δεν υπάρχουν σχόλια:
Δημοσίευση σχολίου
Όλα τα σχόλια θα εμφανίζονται μετά την έγκρισή τους από τους διαχειριστές του Astakos-News. Υβριστικά σχόλια ή σχόλια που δεν έχουν σχέση με το παραπάνω άρθρο, δεν θα δημοσιεύονται. Τα σχόλια και τα κείμενα των αναγνωστών εκφράζουν τους ίδιους και δεν υιοθετούνται κατ' ανάγκη από την παρούσα ιστοσελίδα.